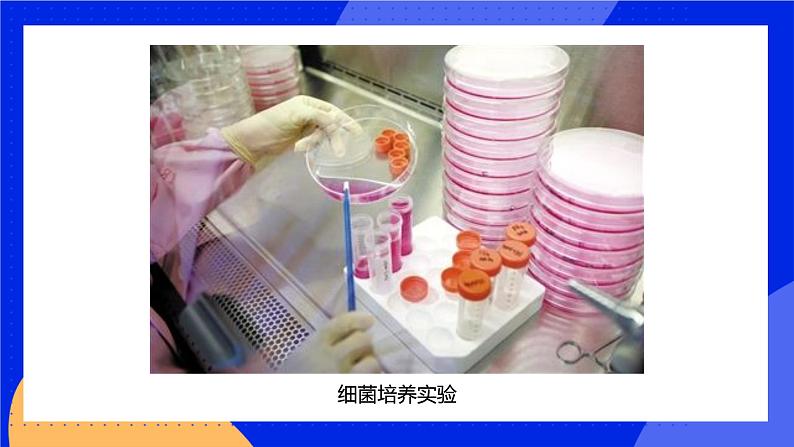

北师大版七年级上册第1节 生物学是探索生命的科学精品ppt课件
展开古希腊有一个叫亚里士多德的哲学家和科学家主观臆断:“家燕在沼泽地带的冰下越冬。” 18世纪,瑞士北部城市巴塞尔一个补鞋匠,和棚下一只雌燕建立了深厚感情。燕子每年秋凉后总要飞走,鞋匠很想弄清它的去向,于是他在燕子脚上附上字条,通过好心人的回复知道了燕子在雅典(希腊首都,位于瑞士之南)过冬,即燕子在温暖的低纬度地区越冬。 以后的研究人员开始给燕子做标记放飞,逐渐掌握了它的迁徙规律。这一方法已被现代许多生物学家采用,还用于海洋动物和陆上动物的研究。
1、了解生物学家的科学活动。2、认识生物学及其发展历程。3、列举生物学研究的对象和研究意义。
观察鱼的内部结构和脑进化的程度
BBC南极皇帝企鹅生态纪录片 超萌“企鹅特务”助拍摄
通过科学工作者们长期不懈的科学活动,生物学不断地发展。
为了生存,远古先民掌握了生物的形态、分类和行为的基本知识,虽然没有文字,这些动植物基本知识被后人代代相传
OUR CHANCE
分类学家将地球上的生物,按照大小和从属关系排列:界、门、纲、目、科、属、种。最小的单位为“种”,每种生物在这种排列中都有自己的分类地位。
常用的五种生物(果蝇、人、豌豆、酿酒酵母和大肠杆菌)的名称和分类
生物由低级到高级、由简单到复杂的演变过程
跳动的心脏,让血液在动脉和静脉之间循环
1953年,美国生物化学家沃森(James Dewey Watsn,1928~)和英国生物物理学家克里克(Francis Harry Cmptn Crick,1916~)提出了最伟大的模型——DNA双螺旋结构模型。
生物学的研究对象是生命现象
1、生物科学是自然科学中的一门基础科学,它是研究生物的形态、结构、分类、生理、遗传和变异、进化、生态的科学。 2、生物科学是一门实验科学,一切生物学知识都来源于对大自然的观察与实验。
Add a title
国际上把杂交水稻当作中国继四大发明之后的第五大发明,誉为“第二次绿色革命”。你知道被称为“杂交水稻之父”的生物学家是谁吗?谈谈你对他的认识?
提示:此生物学家是袁隆平。
林奈达尔文哈维沃森和克里克
DNA分子双螺旋结构生物分类系统物种起源与生物进化理论血液循环
实验开始时面包片为什么要在空气中暴露30分钟?
使面包片可以接触空气中的霉菌孢子
温度对霉菌的生长有什么影响?实验结论
霉菌的生长需要适宜的温度。
北师大版七年级上册第1节 生物学是探索生命的科学备课ppt课件: 这是一份北师大版七年级上册第1节 生物学是探索生命的科学备课ppt课件,文件包含21生物学是探索生命的科学pptx、中国科学家mp4、天宫课堂_如何研究失重条件下细胞生长发育mp4、微课屠呦呦mp4、生命应该怎样定义mp4、袁隆平2mp4、袁隆平4mp4、达尔文与进化论mp4、近代植物分类学奠基人--林奈mp4等9份课件配套教学资源,其中PPT共31页, 欢迎下载使用。
初中生物北师大版七年级上册第1节 生物学是探索生命的科学教课课件ppt: 这是一份初中生物北师大版七年级上册第1节 生物学是探索生命的科学教课课件ppt,共21页。PPT课件主要包含了生物学家的科学活动,查阅资料,生物学的发展历程,古代岩画上的狩猎活动,林奈与生物学分类,林奈与生物分类,达尔文与生物进化论,人的进化过程,哈维与血液循环的发现,血液循环示意图等内容,欢迎下载使用。
初中北师大版第一单元 认识生命第2章 探索生命第1节 生物学是探索生命的科学优秀ppt课件: 这是一份初中北师大版第一单元 认识生命第2章 探索生命第1节 生物学是探索生命的科学优秀ppt课件,文件包含121生物学是探索生命的科学pptx、121生物学是探索生命的科学练习解析版docx、121生物学是探索生命的科学练习原卷版docx等3份课件配套教学资源,其中PPT共16页, 欢迎下载使用。